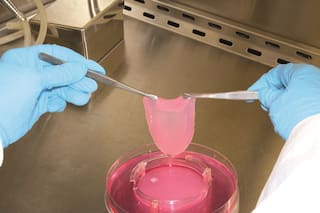
Agroindustria y Biotecnología: no subestimar las amenazas emergentes

Federico Caeiro
PARA LA NACIONLa generación de empleos “verdes” no solo contribuye a la ecología
Incendios: lo que puede suceder no debe tomarnos por sorpresa
La ciudad de los semáforos invisibles
Falta un agenda ambiental de largo plazo
Urge una solución al conflicto mapuche
Agroindustria y Biotecnología: no subestimar las amenazas emergentes
Más leídas
- 1
Nuevo triunfo del cine argentino en los Goya: Belén ganó como mejor película iberoamericana
- 2
Julián Alvarez le dio el triunfo a Atlético de Madrid sobre Oviedo con un gol en el último minuto
3Murió Néstor Otero, el empresario “intocable” que explicaba cómo funciona la complicidad entre los negocios y el poder
4La Rosadita de la AFA: videos y fotos revelan cómo se movía el dinero en cajas, bolsas y mochilas